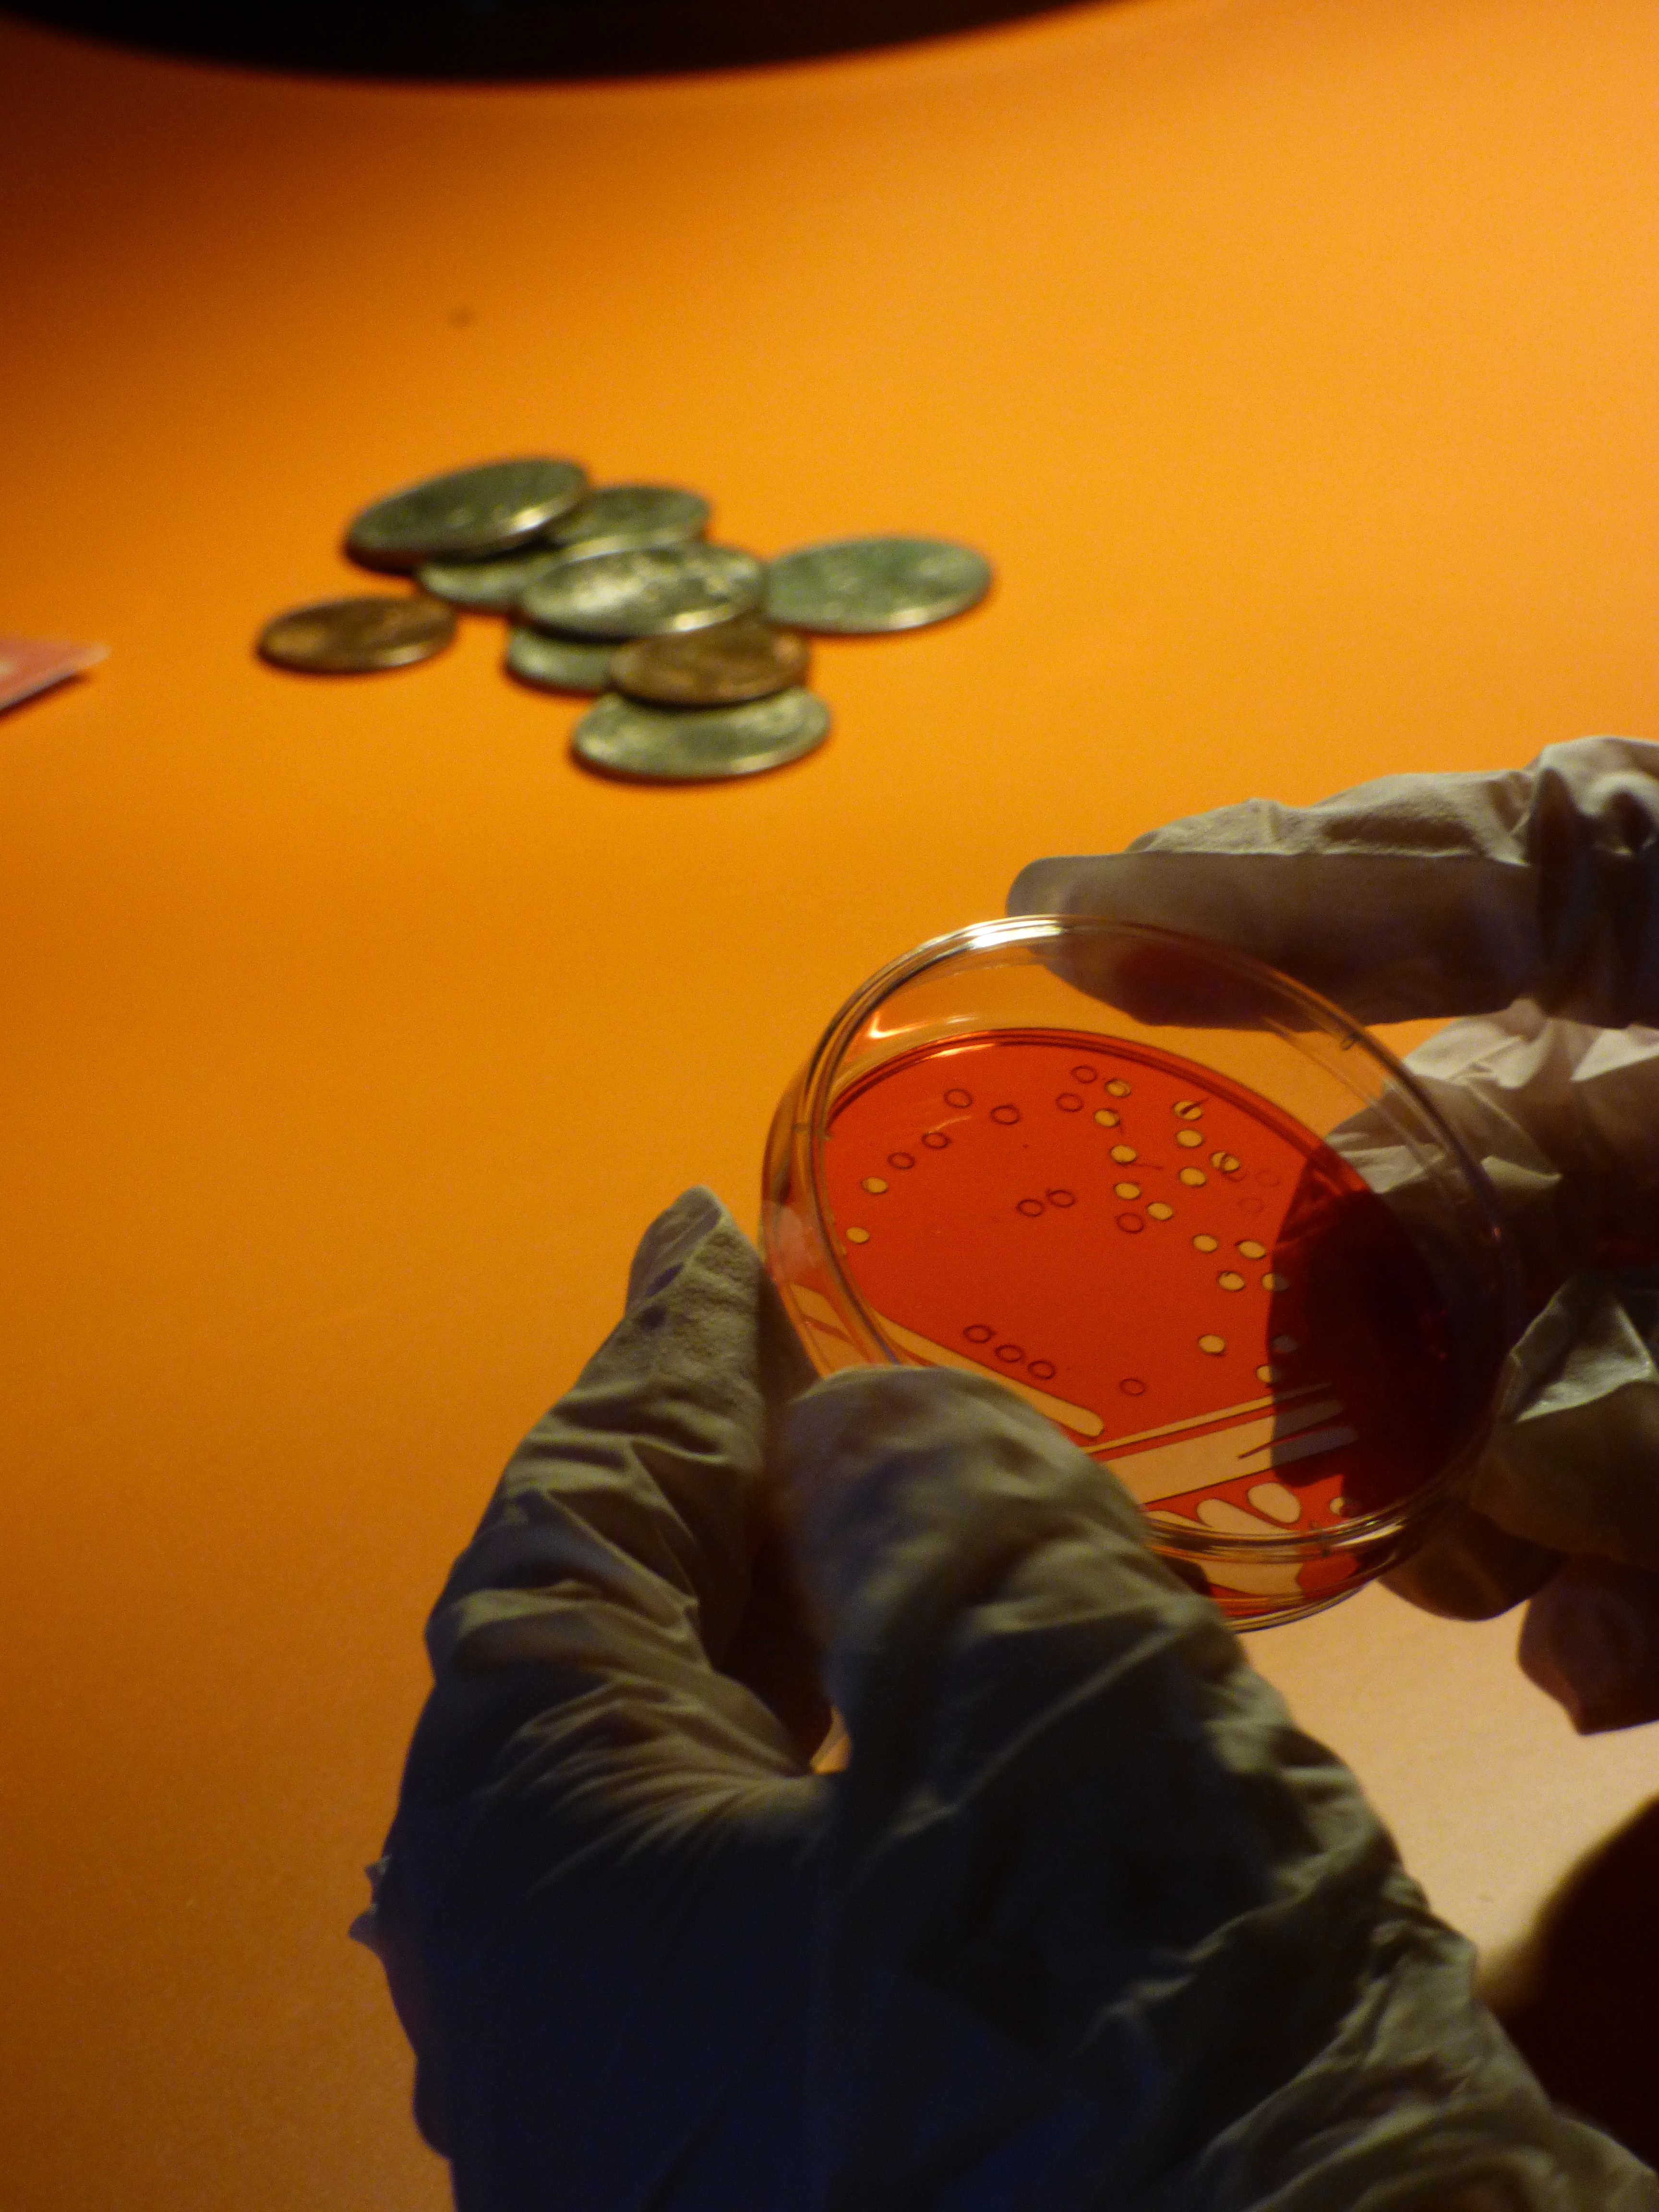

The Pathogen of War
30 mins, Multimedia, 2024
Today, in 2024, Acinetobacter baumannii is one of the most antibiotic resistant pathogens and is estimated to kill between 50,000-100,000 people a year. This interactive work extrapolates from real biography and science to create a speculative but possible near future, exploring the causes and dangers of antibiotic resistance.
The Pathogen of War takes you forward to 2073, a time after the Bio-Rift - the period when all bacteria became resistant to our antibiotics, resulting in the deaths of around half the human population. Set in the future “Museum of Medical Archaeology", the show outlines the causes of the Bio-Rift and explores how war has biological consequences which can threaten the viability of antibiotics, and our health, globally.
Iraqi doctor turned medical anthropologist Dr. Omar Dewachi takes the audience on a personal journey through Iraq’s recent history, and on how Acinetobacter baumannii went from being a relatively benign bacteria, to a “perfect killer”, also known by its US moniker ‘Iraqibacter’ or the ‘invisible enemy’.
The show reveals the many layers of this bacteria’s social history – from the microscopic to the geopolitical, unearthing how the consequences of war can drive pathogens, which threaten the viability of antibiotics, and our health, globally.
World Premiere at CPH:Dox Inter:Active Exhibition March 2024
Winner of FORUM DES IMAGES - NEWIMAGES AWARD at CPH:DOX 2022


Press
Featured in Art of Life - BBC Arabic
More information at Black Leaf Films
Director: Yasmin Fedda
Writers: Yasmin Fedda & Dan Davies
Creative Technologist: Gavin Morris / Xavier Velastin
Sound designer and Composition: James Bulley
Touch Designer and GFX: Pierangelo Pirak & Vincenzo Siracusano
Production assistant Fisayo Ademiluyi & Amaya Gonzalez
Set designer: Isobel Power Smith
Interactive Consultant/Theatre director - Ryan Van Winkle
Producer - Dan Davies, Black Leaf Films
Executive Producers: Anagram
The Pathogen of War by Yasmin Fedda was developed with CPH:Lab at CPH:Dox (2021/22), and through a residency at the National Theatre Immsersive Story Telling Studio (NTISS) in 2023, in collaboration with Anagram.
Assistant Producer, National Theatre Immersive Storytelling Studio: Benjamin Smith
Head of Immersive Storytelling Studio: Toby Coffey
Preview commissioned by Shubbak: A Window on Contemporary Arab Cultures (2023), supported by Battersea Arts Centre
Supported by Queen Mary University of London
A Production of Black Leaf Films
